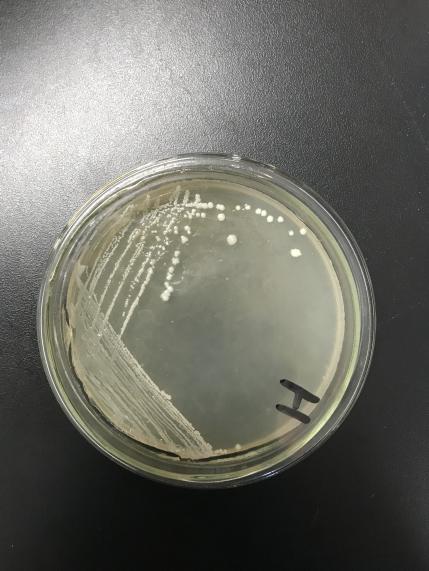

自然界中脂肪酶高产菌株的筛选与鉴定毕业论文
2020-04-16 16:44:25
摘 要
Abstract II
第一章文献综述 1
1.1 脂肪酶简介 1
1.2 常见产脂肪酶菌株 1
1.2.1 洋葱伯克霍尔德菌 1
1.2.2 黑曲霉 2
1.2.3克雷伯氏菌 2
1.3 常用脂肪酶活测定方法 2
1.3.1 平板显色法 2
1.3.2酸碱指示剂滴定法 2
1.3.3分光光度法 2
1.3.4 浊度测定法 3
1.4Biolog微生物鉴定 3
1.5实验研究目的和意义 3
第二章实验材料与方法 5
2.1材料 5
2.1.1试剂与器材 5
2.1.2培养基 6
2.2方法 6
2.2.1 土壤处理 6
2.2.2富集培养 6
2.2.3菌株筛选 7
2.2.4菌种鉴定 7
2.3 产酶条件优化 9
2.3.1脂肪酶酶活定量测定方法 9
2.3.2发酵培养基优化 9
2.3.3发酵条件的优化 10
第三章 结果与讨论 11
3.1目标菌株的筛选结果 11
3.2脂肪酶产生菌菌种鉴定结果 12
3.3产酶条件优化结果 12
3.3.1发酵培养基优化结果 12
3.3.2发酵培养条件的优化 13
第四章 结论与展望 17
4.1 结论 17
4.2 展望 17
参考文献 18
致谢 21
第一章 文献综述
1.1 脂肪酶简介
脂肪酶(三酰基甘油酰基水解酶)可以催化由甘油和长链脂肪酸形成的酯的水解和合成。脂肪酶在自然界中广泛存在,但仅限于此微生物脂肪酶具有商业意义[1]。 脂肪酶的许多应用包括在食品、皮革、医药和洗涤剂行业[2]、特殊有机合成,脂肪和油的水解,脂肪的改性,食物中的风味增强加工,化学分析和分辨率等许多工业领域中均有应用[3]。鉴于对脂肪酶及其在高价值合成中的许多应用和作为大量酶的日益了解,这些酶对生物加工的影响越来越大[4]。
1.2 常见产脂肪酶菌株
脂肪酶的来源十分广泛,微生物是其中一个重要来源,目前已报发现够产脂肪酶的微生物大约有65个属,其中细菌28个属、放线菌4个属、酵母菌10个属、其他真菌23个属,但实际上,脂肪酶在微生物界的分布远超过此,目前还不断发现报道新的产脂肪酶的微生物[5]。
表1 -1已知的高产脂肪酶菌株
发现人 | 菌株来源 | 菌株名称 | 酶活 |
徐伟芳等[6] | 食堂附近 | 甲基营养型芽孢杆菌 | 5.67U/mL |
王乐等[7] | 油脂厂餐厅附近 | 克雷伯氏菌 | 11U/mL |
夏宇等[8] | 实验室现有菌株 | 白地霉菌 | 10.79 U/mL |
林仙菊等[9] | 食堂附近 | 洋葱伯克霍尔德菌 | 12.71 U/m L |
李军红等[10] | 炼油作坊附近 | 黑曲霉 | HC=1.6 |
付瑞敏等[11] | 榨油厂附近 | 醋酸钙不动杆菌 | HC=2.21 |
1.2.1 洋葱伯克霍尔德菌
洋葱伯克霍尔德菌脂肪酶(B.cepacia lipase, BCL) 对多种有机溶剂(醇)、热、氧化剂、表面活性剂、去污剂、蛋白酶等有较好抗性, 是目前在有机合成、洗涤剂添加剂和非水相催化中应用最为广泛的脂肪酶之一[12]。
1.2.2 黑曲霉
黑曲霉产品和表达异源蛋白具有胞外分泌率高、表达量大、蛋白具有天然活性和蛋白修饰模式接近高等真核生物等优点,黑曲霉作为细胞工厂,广泛应用于酶制剂、异源蛋白、有机酸等生产领域,被美国FDA和世界卫生组织认定为一般认为安全可靠无毒的(Generally regarded as safe,GRAS)微生物[13]。
1.2.3克雷伯氏菌
克雷伯氏菌广布于土壤、水体、谷物等自然环境以及生物体的消化、呼吸系统中,克雷伯氏菌属于革兰氏阴性菌,根据近几年相关研究与报道, 其在污水处理及重金属治理方面具有很强的应用潜力[14]。
1.3 常用脂肪酶活测定方法
1.3.1 平板显色法
平板显色法的原理为脂肪酶与三丁酸甘油酯[15]或橄榄油乳化底物发生降解,从而产生透明圈。通过比较透明圈与菌落直径记为HC值可以大概比较出脂肪酶活力大小。该方法步骤简单,能够进行多种菌种同时测量挑选出酶活较大的菌株,可进行批量操作。但该方法受到底物和测量过程影响,测试结果不是特别稳定。
1.3.2酸碱指示剂滴定法
酸碱滴定法的原理为利用碱液滴定脂肪酶催化底物橄榄油乳化液时生成的脂肪酸,待测定的脂肪酶酶活可以通过滴定消耗的碱液可以较为简便地计算[16]。该方法操作简单,所需试剂安全无污染,能较快得出数据,适用于多种情形。但由于橄榄油乳化体系存在不稳定易分层的缺点并且油乳液中微粒大小和浓度是酶活力测定的影响因素,同时因为该方法消耗碱液体积不够大量,并且滴定时反应到达终点时瓶内试剂变色无法准确判断造成该检测方法结果不够准确。
1.3.3分光光度法
该方法的原理为利用铜皂在715nm附近处吸收可见光形成有一宽的吸收峰,通过苯萃取的方法萃取测量待测脂肪酶产生的脂肪酸与铜离子发生反应形成的铜皂,然后进行比色测定来测定酶活大小[17]。对硝基苯酚比色法是利用溶液中对硝基苯酚的浓度与溶液的颜色成倍数线性关系,在适宜的温度和pH条件下,测量待测脂肪酶分解硝基苯酯类反应底物生成有黄色的对硝基苯酚在410 nm处测量得到的溶液的吸光度值,制作对硝基苯酚-吸光度标准曲线后代入, 计算出脂肪酶的酶活力。该方法测量酶活更精准,灵敏度高,但该方法需要消耗大量苯,易对环境和试验人员产生影响。同时若待测粗酶液中含有其他成分未明的杂质,溶液不纯,则会影响所测数据。
1.3.4 浊度测定法
浊度测定法的原理为利用脂肪酶分解吐温-20形成脂肪酸,同时与底物溶液中存在的CaCl2结合生成钙盐,作为沉淀析出,因此改变了溶液的光密度[18]。通过监测500 nm处光密度的变化,以此来测量待测粗酶液的酶活大小。该方法操作简便,试剂也较为安全,能较快得出结论,但由于与脂肪酸与CaCl2结合过程不可控,可能会生成其它复合物[19],会影响酶活测定的结果。
1.4Biolog微生物鉴定
Biolog生物自动化微生物分析系统的识别原理是各种不同类型的微生物特定于碳源的使用。当微生物使用碳源生成酶时,如氧化还原酶能够使四唑着色被还原成紫色四唑类,产生明显的颜色变化。将待检测的微生物接种于特定的微生物鉴定培养基内,反应一段时间后,检测颜色变化来确定待测菌株种类。同时,在待测微生物于特定平板上培养期间,由于微生物不断增殖代谢消耗碳源,培养基内浊度也会随之发生变化。根据上述原理,Biolog已经创建了每种微生物的独特指纹,该指纹是对应于微生物类型的数据库。在鉴定时,将被检测的微生物与数据库内储存的指纹图谱进行比较分析,智能软件将获得待测微生物的鉴定结果[20]。
1.5实验研究目的和意义
本实验的目的是从自然界内富含油脂或周围有油污排出的工厂食堂附近,提取出产脂肪酶菌株,测定其脂肪酶活,探究不同因素对其生长、脂肪酶活性的影响。通过本次试验,可以得出最适的脂肪酶培养条件和最适培养级配方。目前由于食品加工企业和餐饮业的飞速发展,带来的不仅是经济发展还有大量富含油脂的生产废弃排放物,这些富含油脂的排放物已经成为自然资源污染的罪魁祸首之一。由大量的实验可知,采用微生物产脂肪酶对富含油脂的废弃排放物进行降解得到良好的效果。本实验对所筛脂肪酶进行酶学性质的研究以及发酵条件的探究,为了以后进一步挑选培育出酶活更高、应用更加高效的脂肪酶。
第二章 实验材料与方法
2.1材料
土壤样品来源:采自龙华美食街附近。
2.1.1试剂与器材
如表2-1、2-2所示。
表2-1试剂名称
试剂名称 | 纯度规格 | 生产厂家 |
酵母浸粉 | BR | 北京奥博星生物技术有限责任公司 |
磷酸二氢钾 | AR | 国药集团化学试剂有限公司 |
硫酸镁,七水 | AR | 国药集团化学试剂有限公司 |
氯化钠 | AR | 西陇化工股份有限公司 |
磷酸氢二钾 | AR | 上海凌峰化学试剂有限公司 |
橄榄油 | CP | 上海凌峰化学试剂有限公司 |
胰蛋白胨 | BR | 北京奥博星生物技术有限责任公司 |
聚乙烯醇 | AR | 国药集团化学试剂有限公司 |
蛋白胨 | BR | 北京奥博星生物技术有限责任公司 |
磷酸氢二钠 | AR | 上海凌峰化学试剂有限公司 |
琼脂粉 | BR | 国药集团化学试剂有限公司 |
表2-2实验仪器
仪器设备 | 型号 | 生产厂家 |
隔水式电热恒温培养箱 | PYX-DHS | 上海跃进医疗器械有限公司 |
立式压力蒸汽灭菌锅 | YXQ-LS-50SⅡ | 上海博讯实业有限公司医疗设备厂 |
台式高速离心机 | TG16-WS | 济南来宝科学仪器有限公司 |
电子天平 | FA2004 | 上海舜宇恒平科学仪器有限公司 |
pH计 | PHS-3C | 上海仪电科学仪器股份有限公司 |
数显恒温水浴锅 | HH-6 | 江苏省金坛市荣华仪器制造有限公司 |
台式恒温振荡器 | THZ-320 | 上海精宏实验设备有限公司 |
生物显微镜 | XS-202-212 | 南京江南永新光学有限公司 |
洁净工作台 | SW-CJ-1FD | 苏州安泰空气技术有限公司 |
2.1.2培养基


2.2方法
2.2.1 土壤处理
称取1g所采集的土壤,用研钵将其碾碎,加入配置好的10mL0.9%的生理盐水中。采用均质机进行充分振荡,静置。
2.2.2富集培养
吸取1mL2.2.1所得上清液,加入富集培养基1号中,放置于恒温震荡培养箱内,于37℃,150r/min条件下培养24h后,吸取1mL 培养基1号中液体加入富集培养基2号中,在相同条件下培养24 h后,吸取1 mL培养基2号中液体加入富集培养基3号中,在同等条件下培养24 h,完成富集培养。
2.2.3菌株筛选
吸取1 mL2.2.2中所得富集菌液,加入9mL的已经灭菌处理过的生理盐水试管中作为10-2稀释度,振荡试管使溶液混合均匀。再吸取1 mL,连续10倍梯度稀释,吸取10-5,10-6,10-7三个浓度菌液200 μL,采用平板涂布法将其涂布于初筛培养基上,于37℃恒温条件下,培养72h~96h。放置于紫外线观察箱中,于350nm处观察培养基内是否有荧光圈。观察到荧光圈后使用游标卡尺分别测量产生荧光圈的菌落直径和荧光圈直径大小,并计算荧光圈直径与菌落直径的比值,所得值为HC。
2.2.5 菌种鉴定
挑取2.2.4中筛选出的脂肪酶生产菌株接种于PDA培养基,37℃恒温培养箱培养24h~48h,观察菌落形态等生理特征特征。进行革兰氏染色以及biolog微生物鉴定。
以上是毕业论文大纲或资料介绍,该课题完整毕业论文、开题报告、任务书、程序设计、图纸设计等资料请添加微信获取,微信号:bysjorg。
相关图片展示:

您可能感兴趣的文章
- 布里奇果油纳米乳液在等渗运动饮料中应用的可行性外文翻译资料
- 茶多酚类作为呋喃抑制剂在美拉德模型系统和罐装咖啡模型的形成外文翻译资料
- 实用型重组杂交贻贝生物粘合剂fp-151外文翻译资料
- COI条形码在我国市场常见鱼类品种鉴定中的应用毕业论文
- DNA条形码在我国市场常见虾蟹品种鉴定中的应用毕业论文
- 基于SYBR-Green-I荧光定量PCR技术鉴定我国常见虾蟹品种方法的建立毕业论文
- 微型COI条形码在我国市场常见虾蟹类品种鉴定中的应用毕业论文
- 水稻体内敌草隆液相检测方法建立及外源茉莉酸对其在水稻体内代谢的影响毕业论文
- 蛋白饮料经高压静电处理后蛋白质的变化毕业论文
- 核酸茎环结构用于电化学快速检测肠毒素毕业论文


